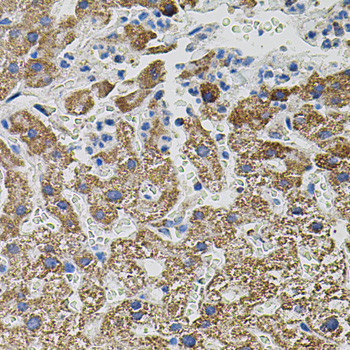
NTF3 Antibody in Immunohistochemistry (Paraffin) (IHC (P))

Search
Invitrogen
NTF3 Polyclonal Antibody
{{$productOrderCtrl.translations['antibody.pdp.commerceCard.promotion.promotions']}}
{{$productOrderCtrl.translations['antibody.pdp.commerceCard.promotion.viewpromo']}}
{{$productOrderCtrl.translations['antibody.pdp.commerceCard.promotion.promocode']}}: {{promo.promoCode}} {{promo.promoTitle}} {{promo.promoDescription}}. {{$productOrderCtrl.translations['antibody.pdp.commerceCard.promotion.learnmore']}}
图: 1 / 3
NTF3 Antibody (PA5-88570) in IHC (P)



Please note: We are reviewing Western blot images included in the antibody testing data in our catalog, including those provided by third parties. Unless expressly labeled or annotated as “raw-unedited”, Western blot images included in the antibody testing data in our catalog may have been edited, optimized or otherwise adjusted for presentation.
产品信息
PA5-88570
种属反应
宿主/亚型
分类
类型
抗原
偶联物
形式
浓度
规格
纯化类型
保存液
内含物
保存条件
运输条件
RRID
产品详细信息
Immunogen sequence: NNMDQRSLPE DSLNSLIIKL IQADILKNKL SKQMVDVKEN YQSTLPKAEA PREPERGGPA KSAFQPVIAM DTELLRQQRR YNSPRVLLSD STPLEPPPLY LMEDYVGSPV VANRTSRRKR YAEHKSHRGE YSVCDSESLW VTDKSSAIDI RGHQVTVLGE IKTGNSPVKQ YFYETRCKEA RPVKNGCRGI DDKHWNSQCK TSQTYVRALT SENNKLVGWR WIRIDTSCVC ALSRKIGRT; Positive Samples: Jurkat, SW480, SKOV3, MCF7
靶标信息
The protein encoded by this gene is a member of the neurotrophin family, that controls survival and differentiation of mammalian neurons. This protein is closely related to both nerve growth factor and brain-derived neurotrophic factor. It may be involved in the maintenance of the adult nervous system, and may affect development of neurons in the embryo when it is expressed in human placenta. NTF3-deficient mice generated by gene targeting display severe movement defects of the limbs. The mature peptide of this protein is identical in all mammals examined including human, pig, rat and mouse.
仅用于科研。不用于诊断过程。未经明确授权不得转售。
篇参考文献 (0)
生物信息学
蛋白别名: HDNF; Nerve growth factor 2; Neurotrophic factor; Neurotrophin-3; NGF-2; NT-3
基因别名: AI316846; AI835689; Nt3; Ntf-3; Ntf3
UniProt ID: (Mouse) P20181
Entrez Gene ID: (Mouse) 18205